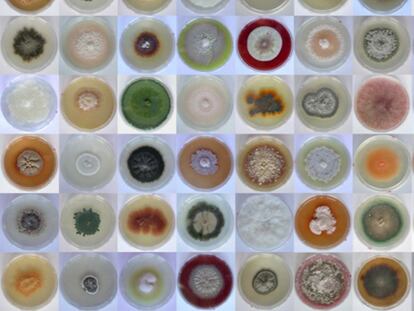

Noches de sol en Islandia
La mejor época para viajar al país va desde junio hasta mediados de agosto
La mejor época para viajar al país va desde junio hasta mediados de agosto
El PP controlará el 82% de los 179 municipios de la región, frente al 11% del PSOE
Los socialistas tendrán apenas 20 municipios frente a 149 del PP - No logran pactos de gobierno en Coslada, Getafe ni Leganés
Un seminario explica las claves para entrar en el mercado laboral germano
Los populares incumplen en Negreira la promesa de que gobierne el más votado